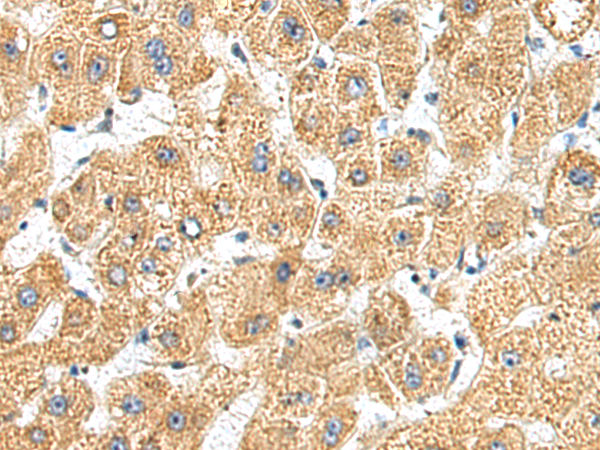
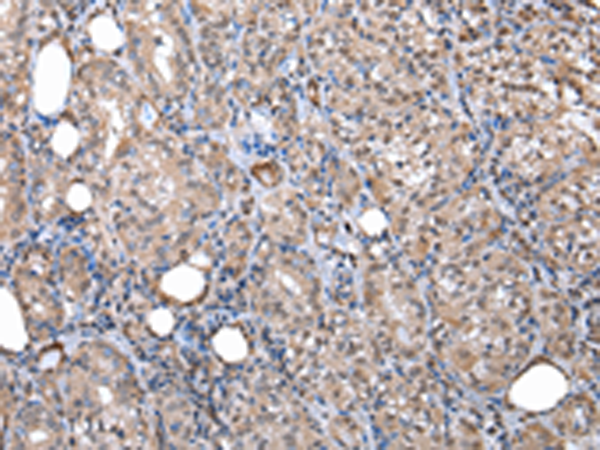

-
分类: 科研抗体货号: P01968别名: HCG-1; PNSC1应用: IHC反应种属: Human, Mouse, Rat
-
分类: 科研抗体货号: P01960别名: UAP; UBAP; NAG20; UBAP-1应用: IHC反应种属: Human, Mouse, Rat
-
分类: 科研抗体货号: P02040别名: GRNG; HCCA1; HCCA2; YY1AP应用: WB,IHC反应种属: Human, Mouse
-
分类: 科研抗体货号: P01946别名: EGP1; GP50; M1S1; EGP-1; TROP2; GA7331; GA733-1应用: IHC反应种属: Human, Mouse, Rat
-
分类: 科研抗体货号: P02037别名: XRG6; C8orf5; C8orf7; C8orf21应用: IHC反应种属: Human, Mouse, Rat
-
分类: 科研抗体货号: P02106别名:应用: IHC反应种属: Human, Mouse
-
分类: 科研抗体货号: P01939别名: C5FW; TRB2; GS3955应用: IHC反应种属: Human, Mouse
-
分类: 科研抗体货号: P02032别名: SWIP1; WSB-1应用: IHC反应种属: Human, Mouse
-
分类: 科研抗体货号: P02101别名: COBP应用: IHC反应种属: Human
-
分类: 科研抗体货号: P01927别名: DIL2; p100; DIL-2; HCTP4; FLS353; HCA519; REPP86; C20orf1; C20orf2; GD:C20orf1应用: WB反应种属: Human, Mouse

鄂公网安备42018502007531号
鄂公网安备42018502007531号

